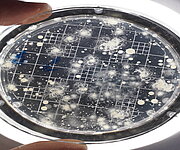

- Start
- Informationen
- Jahresbericht 2025
-
Lösungen
-
 Wasseranalytik Physikalisch-chemische und mikrobiologische Wasseruntersuchungen nach Trinkwasserverordnung und anderen relevanten Vorgaben durchführen und bewerten.
Wasseranalytik Physikalisch-chemische und mikrobiologische Wasseruntersuchungen nach Trinkwasserverordnung und anderen relevanten Vorgaben durchführen und bewerten. -
 Prüfung von Produkten und Geräten Erstprüfungen von Produkten und Materialien im Kontakt mit Trinkwasser. Die Prüfstelle ist für über 200 Produktnormen nach DIN EN ISO 17025 akkreditiert.
Prüfung von Produkten und Geräten Erstprüfungen von Produkten und Materialien im Kontakt mit Trinkwasser. Die Prüfstelle ist für über 200 Produktnormen nach DIN EN ISO 17025 akkreditiert. -
 Aufbereitungstechnologien Nachhaltige und sichere Wasserversorgungskonzepte erarbeiten. Neue Technologien zur Trinkwasseraufbereitung realisieren, überwachen und optimieren.
Aufbereitungstechnologien Nachhaltige und sichere Wasserversorgungskonzepte erarbeiten. Neue Technologien zur Trinkwasseraufbereitung realisieren, überwachen und optimieren. -
 Stoffe und Mikroorganismen Bestimmungsverfahren moderner Methoden entwickeln und verbessern. Vorkommen, Verhalten und Verbleib anorganischer und organischer Spurenstoffe untersuchen.
Stoffe und Mikroorganismen Bestimmungsverfahren moderner Methoden entwickeln und verbessern. Vorkommen, Verhalten und Verbleib anorganischer und organischer Spurenstoffe untersuchen. -
 Netzmanagement und Trinkwasserinstallation Beratung zur Sicherung der Trinkwasserbeschaffenheit im Verteilungssystem, Unterstützung bei der Entwicklung von spezifischen Netzmanagementstrategien.
Netzmanagement und Trinkwasserinstallation Beratung zur Sicherung der Trinkwasserbeschaffenheit im Verteilungssystem, Unterstützung bei der Entwicklung von spezifischen Netzmanagementstrategien. -
 Risikomanagement Unterstützung von Wasserversorgungsunternehmen beim Risikomanagement für Wasserversorgungsanlagen, basierend auf unserer umfassenden Expertise.
Risikomanagement Unterstützung von Wasserversorgungsunternehmen beim Risikomanagement für Wasserversorgungsanlagen, basierend auf unserer umfassenden Expertise. -
 Trinkwasserressourcen und Einzugsgebiete Schutz der Trinkwasserressourcen durch Bewerten potenzieller Gefährdungen in Wassereinzugsgebieten, Maßnahmenkataloge, Monitoringkonzepte, Datenbanken.
Trinkwasserressourcen und Einzugsgebiete Schutz der Trinkwasserressourcen durch Bewerten potenzieller Gefährdungen in Wassereinzugsgebieten, Maßnahmenkataloge, Monitoringkonzepte, Datenbanken. -
 Umweltbiotechnologie und Altlasten Umweltbiotechnologie zur Verbesserung der Wasserqualität. Abbauprozesse zur Wasserreinigung. Konzepte und Machbarkeitsstudien bei Schadstoffbelastungen.
Umweltbiotechnologie und Altlasten Umweltbiotechnologie zur Verbesserung der Wasserqualität. Abbauprozesse zur Wasserreinigung. Konzepte und Machbarkeitsstudien bei Schadstoffbelastungen. -
 Digitalisierung Lösung von Fragen und Problemen von Wasserversorgungsunternehmen bei der Digitalisierung durch fachliche Unterstützung oder praxisnahe Forschungsprojekte.
Digitalisierung Lösung von Fragen und Problemen von Wasserversorgungsunternehmen bei der Digitalisierung durch fachliche Unterstützung oder praxisnahe Forschungsprojekte. -
 Praxisprojekte Forschung und Praxis, Wasserforschung, wissenschaftlich-technische Expertisen, Technologiekonzepte, Ressourcenschutz, Verteilnetz, Digitalisierung.
Praxisprojekte Forschung und Praxis, Wasserforschung, wissenschaftlich-technische Expertisen, Technologiekonzepte, Ressourcenschutz, Verteilnetz, Digitalisierung.
-
-
Forschung
-
 Ressourcenschutz Nachhaltiger Schutz der Wasserressourcen für eine sichere Trinkwasserversorgung, Management von Gefährdungen und Risiken in Wassereinzugsgebieten.
Ressourcenschutz Nachhaltiger Schutz der Wasserressourcen für eine sichere Trinkwasserversorgung, Management von Gefährdungen und Risiken in Wassereinzugsgebieten. -
 Umweltbiotechnologie Technische und biologische Methoden zur Elimination von Mikroorganismen, mikrobiologische Abbauprozesse, Risikoabschätzung mikrobieller Kontamination.
Umweltbiotechnologie Technische und biologische Methoden zur Elimination von Mikroorganismen, mikrobiologische Abbauprozesse, Risikoabschätzung mikrobieller Kontamination. -
 Mikroorganismen Anwendung und Entwicklung zuverlässiger Nachweismethoden von Mikroorganismen im Trinkwasser, Desinfektions- und Aufbereitungsmaßnahmen bewerten.
Mikroorganismen Anwendung und Entwicklung zuverlässiger Nachweismethoden von Mikroorganismen im Trinkwasser, Desinfektions- und Aufbereitungsmaßnahmen bewerten. -
 Spurenstoffe Spurenstoffe und Mikroplastik sicher und sensitiv bestimmen, Verhalten im Wasserkreislauf untersuchen und qualifizierte Stoffbewertung abgeben.
Spurenstoffe Spurenstoffe und Mikroplastik sicher und sensitiv bestimmen, Verhalten im Wasserkreislauf untersuchen und qualifizierte Stoffbewertung abgeben. -
 Abwasser und Wasserkreislauf Integrierte Wasserver- und Abwasserentsorgungskonzepte erarbeiten, Nutzung biologischer Abbauprozesse zur Elimination persisitenter Substanzen.
Abwasser und Wasserkreislauf Integrierte Wasserver- und Abwasserentsorgungskonzepte erarbeiten, Nutzung biologischer Abbauprozesse zur Elimination persisitenter Substanzen. -
 Neue Technologien und Produkte Technologien und Produkte zur Aufbereitung, Desinfektion und Nachbehandlung von Trinkwasser, Prüfung auf Leistungsfähigkeit, Sicherheit und Robustheit.
Neue Technologien und Produkte Technologien und Produkte zur Aufbereitung, Desinfektion und Nachbehandlung von Trinkwasser, Prüfung auf Leistungsfähigkeit, Sicherheit und Robustheit. -
 Asset-Management und Infrastruktur Entwicklung von Asset-Managementstrategien zur Sicherung stabiler Trinkwasserbereitstellung, Zustandsbewertung von Leitungsnetzen und ihrer Bestandteile.
Asset-Management und Infrastruktur Entwicklung von Asset-Managementstrategien zur Sicherung stabiler Trinkwasserbereitstellung, Zustandsbewertung von Leitungsnetzen und ihrer Bestandteile. -
 Digitalisierung und Management Digitalisierung in den Bereichen der Datenerfassung, Datenhaltung, datengetriebene Applikationen und Künstliche Intelligenz für die Wasserversorgung.
Digitalisierung und Management Digitalisierung in den Bereichen der Datenerfassung, Datenhaltung, datengetriebene Applikationen und Künstliche Intelligenz für die Wasserversorgung.
-
- Projekte
- Das TZW
- Informationen
- Veranstaltungen
- Karriere